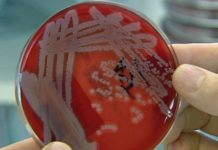
CPS crea conciencia sobre la leptospirosis

Port St. Maarten y la Oficina de Turismo asistieron al Congreso Ejecutivo CLIA.
FOTO: Rosina Lynch - Cruise & Yachting ops, Lane West, Gerente CLIA, Socio, Lela Simmonds - Oficial Corporativo, Bo Larsen - Vicepresidente Senior, Asociaciones...
Consejos de seguridad para decorar su hogar y su árbol de Navidad
GREAT BAY, Sint Maarten (DCOMM) – Las personas se aprestan en esta época navideña a comprar sus árboles de Navidad y luces para adornar...
Policía de Anguila solicita información sobre la muerte de Sulamita Fleming-Concepción
ANGUILA - La Policía Real de Anguila continúa solicitando la asistencia del público en general en su investigación en curso sobre la muerte de...
La ex propietaria del Trust Standard Corinne de Tullio fue arrestada bajo investigación de...
PHILIPSBURG, Sint Maarten.- Corinne de Tullio (54 años, Aruba), propietaria de una antigua oficina fiduciaria en Sint Maarten, fue arrestada hoy, domingo 10 de...
Se instalarán dos grandes carpas en el aeropuerto SXM para acomodar a los pasajeros
FOTO: Carpa grande en el aeropuerto SXM
FOTO: Michel Hyman, Director de Operaciones y Director Ejecutivo interino del aeropuerto
AEROPUERTO, St. Maarten - El Aeropuerto Internacional...
Trabajos de demolición justo a ser comenzados en el aeropuerto SXM
AEROPUERTO, St. Maarten .- Se espera que los trabajos comiencen esta semana con la demolición de las paredes interiores del edificio de la terminal...
Incendio en el vertedero: Se les aconseja a las personas con problemas respiratorios cerrar...
GREAT BAY, Sint Maarten (DCOMM).- Parte del relleno sanitario de Pond Island está en llamas.
El Departamento de Bomberos está asesorando a las personas que...
CPS crea conciencia sobre la leptospirosis
GREAT BAY, Sint Maarten (DCOMM).- La leptospirosis es una enfermedad bacteriana que afecta tanto a humanos como a animales. Los humanos se infectan a...
Ombudsman dictamina queja de los vendedores del mercado contra la eliminación de los kioscos...
PHILIPSBURG, Sint Maarten -- Una imagen del mercado turístico de Philipsburg en Dutch St. Maarten, más conocido como el mercado. (Foto en Wikimedia Commons)
Philipsburg.-...
Fallece hombre que fue acuchillado por otro en disputa por un parqueo
Dutch Quarter, St. Maarten.- Un hombre identificado con las iniciales de su nombre S.K., había sino apuñalado en una discusión con otro, falleció ayer...